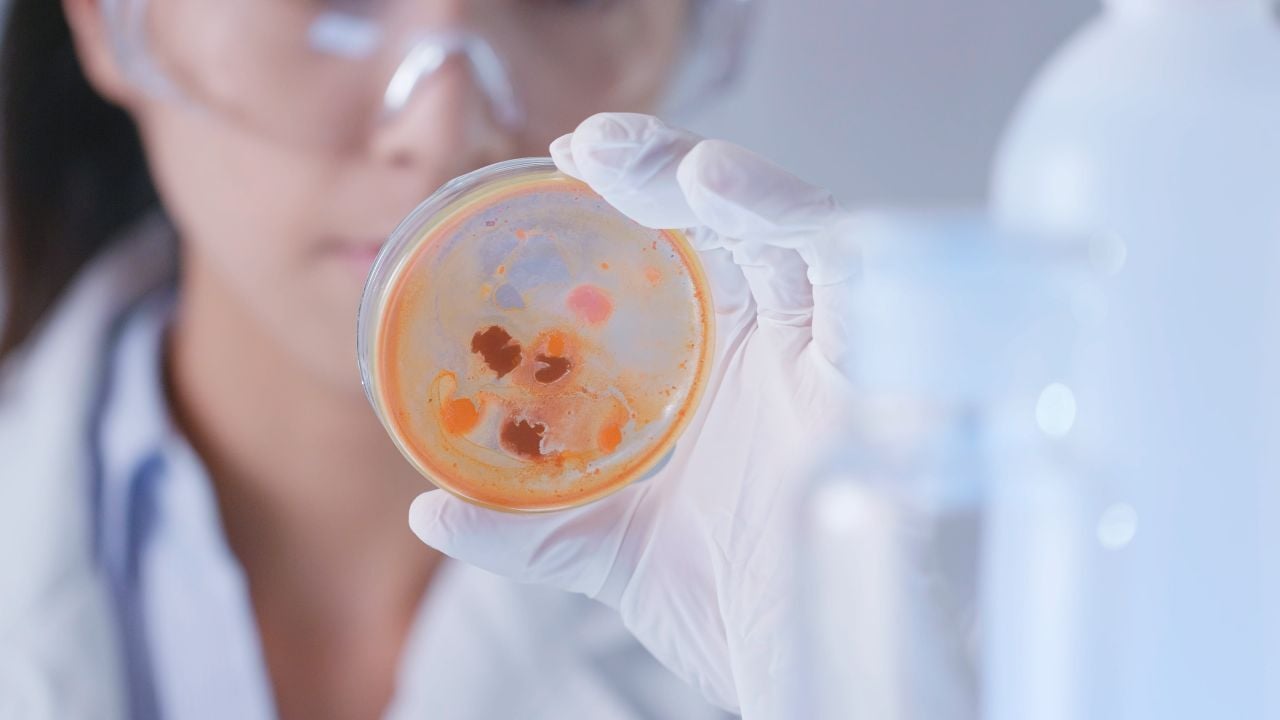
helicobacter-pylori-problemas-digestivos

¿Sientes molestias digestivas frecuentes como acidez, hinchazón o dolor abdominal? Muchas veces estos síntomas se dejan pasar… pero podrían estar relacionados con una bacteria muy común: Helicobacter pylori.
Detectarla a tiempo es clave para evitar complicaciones, y para eso existe una prueba sencilla, rápida y altamente confiable: el test de aliento.

¿Qué es el Test de Aliento y para qué sirve?
El test de aliento, también llamado prueba de aliento con urea, es un examen médico no invasivo que permite detectar la presencia de la bacteria Helicobacter pylori en tu estómago.
Su funcionamiento se basa en una reacción química muy específica. Durante la prueba, ingieres una sustancia que contiene urea con “marcadores especiales”. Si la bacteria está en tu organismo, descompone esa urea y genera dióxido de carbono, que luego se elimina al exhalar.
Este cambio se detecta en tu respiración, permitiendo confirmar la infección de manera precisa.
Puntos clave del Test de Aliento:
-
-
No requiere agujas ni procedimientos invasivos
-
Es rápido y cómodo (dura menos de 30 minutos)
-
Se utiliza tanto para diagnóstico inicial como para confirmar si el tratamiento funcionó
-
Tiene una alta precisión cuando se siguen las indicaciones médicas
Helicobacter pylori: La bacteria detrás de tus problemas digestivos
Helicobacter pylori es una bacteria que vive en el revestimiento del estómago y en la primera parte del intestino delgado. Es más común de lo que parece: muchas personas la tienen sin saberlo.
En la mayoría de los casos no genera síntomas, pero cuando sí lo hace, puede afectar seriamente la salud digestiva.
¿Qué problemas puede causar?
-
-
Gastritis (inflamación del estómago)
-
Úlceras pépticas (llagas en el estómago o intestino)
-
Malestar digestivo persistente
-
A largo plazo, puede aumentar el riesgo de cáncer gástrico
¿Cómo se transmite?
-
-
Contacto con saliva, vómito o heces de una persona infectada
-
Consumo de alimentos o agua contaminados
Sin tratamiento, esta infección puede mantenerse durante años e incluso toda la vida.
Puntos Clave del Test de Aliento
El test de aliento es una de las herramientas más utilizadas hoy para detectar H. pylori, gracias a su combinación de precisión y facilidad.
¿Por qué es tan valorado?
-
-
Es completamente no invasivo
-
Ofrece resultados confiables en poco tiempo
-
Es cómodo para el paciente
-
Permite evaluar si el tratamiento eliminó la bacteria
-
Puede aplicarse en niños mayores de 6 años
Además, al no requerir procedimientos complejos, es ideal como primera opción en muchos casos clínicos.
Preparación para el Test de Aliento: Lo que debes saber
La preparación es un paso clave para asegurar resultados precisos. Algunos medicamentos pueden interferir con la prueba y alterar el resultado.
Indicaciones importantes:
-
-
Evitar antibióticos al menos 4 semanas antes del examen
-
Suspender medicamentos para la acidez (como inhibidores de bomba de protones) hasta 2 semanas antes, si el médico lo indica
-
Evitar ciertos medicamentos como el subsalicilato de bismuto
-
Asistir en ayunas, según indicación médica
Seguir estas recomendaciones ayuda a evitar falsos resultados, especialmente falsos negativos.
Procedimiento del Test de Aliento: Paso a paso
El procedimiento es sencillo, rápido y no genera molestias:
-
Se toma una primera muestra de tu aliento soplando en un recipiente
-
Ingeres una sustancia que contiene urea con carbono especial
-
Esperas unos minutos mientras ocurre la reacción en tu estómago
-
Se toma una segunda muestra de tu aliento
-
Ambas muestras se comparan para detectar cambios
Si la bacteria está presente, el aire que exhalas tendrá una mayor cantidad de dióxido de carbono con el marcador especial. Todo el proceso suele durar entre 20 y 30 minutos.
Fiabilidad y Resultados del Test de Aliento
El test de aliento es considerado una prueba altamente confiable, siempre que se haya realizado correctamente y con la preparación adecuada.
¿Cómo interpretar los resultados?
En caso positivo, el tratamiento suele incluir:
Después del tratamiento, el médico puede solicitar repetir la prueba para confirmar que la infección desapareció completamente.

¿Cuándo se recomienda realizar el Test de Aliento?
Este examen se indica cuando hay sospecha de infección por Helicobacter pylori o cuando se necesita confirmar su eliminación.
Principales motivos para realizarlo:
-
-
Dolor o ardor en la parte superior del abdomen
-
Sensación constante de hinchazón
-
Saciedad precoz (sentirse lleno muy rápido)
-
Náuseas o vómitos
-
Pérdida de apetito o peso sin causa clara
-
Antecedentes de gastritis o úlceras
También es clave en pacientes que ya recibieron tratamiento y necesitan verificar su efectividad.
¿Cómo se compara con otras pruebas de Helicobacter?
Existen varias formas de detectar H. pylori, y cada una tiene su utilidad según el caso.
En la mayoría de los casos, el test de aliento es la opción preferida por su equilibrio entre comodidad y precisión.

Preguntas Frecuentes sobre el Test de Aliento
¿Es doloroso?
No. Es una prueba completamente indolora.
¿Tiene riesgos?
No se conocen riesgos asociados al test de aliento.
¿Cuánto tiempo toma?
Entre 20 y 30 minutos aproximadamente.
¿Puedo hacerlo si estoy tomando medicamentos?
Depende. Algunos medicamentos deben suspenderse antes. Siempre consulta con tu médico.
¿Sirve para confirmar que ya estoy curado?
Sí, es una de las pruebas más utilizadas para verificar que la bacteria fue eliminada.
Muchas veces normalizamos las molestias digestivas, pero tu cuerpo siempre está dando señales. Detectar a tiempo la presencia de Helicobacter pylori puede prevenir complicaciones como úlceras o enfermedades más graves.
En Clínicas Auna, creemos que la prevención y el diagnóstico temprano son fundamentales para cuidar tu bienestar a largo plazo. Si tienes síntomas persistentes, no lo dejes pasar. Consulta con nuestros especialistas en gastroenterología y da el primer paso para cuidar tu salud digestiva.

Fuente:
https://medlineplus.gov/spanish/pruebas-de-laboratorio/pruebas-de-helicobacter-pylori-h-pylori/
https://www.mayoclinic.org/es/diseases-conditions/h-pylori/diagnosis-treatment/drc-20356177
https://medlineplus.gov/spanish/ency/article/007501.htm